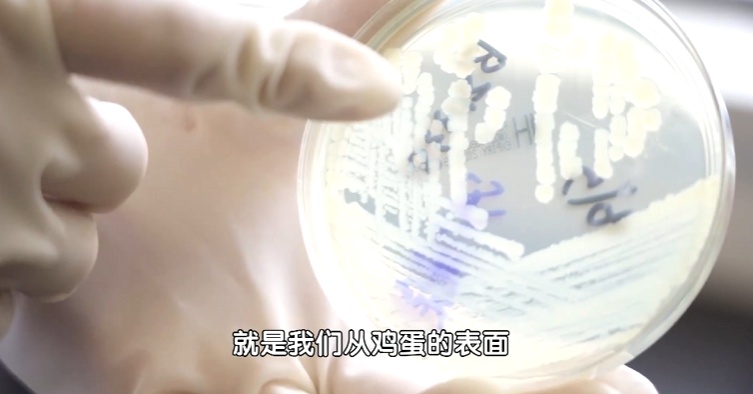
警惕,冰箱里最脏的地方……很多人因此进医院 警惕,冰箱里最脏的地方……很多人因此进医院

生活中,很多人喜欢把家里的冰箱当「保险柜」,吃不完的饭菜、切一半的水果、没喝完的饮料……一股脑都往里塞。
殊不知,当各种食物混杂在一起,冰箱反而可能成为“细菌”的温床,特别是,有个常被漏掉清洁的地方,堪称是「细菌大本营」,它就是——
放鸡蛋的地方(比如蛋架、蛋框等)

1
冰箱细菌“大本营”
放任不管,食材都遭殃
曾经有1项针对家用冰箱的检测发现,冰箱中的金黄色葡萄球菌和大肠杆菌大部分都集中在蛋架上。

研究中冰箱不同部位的常见细菌检测情况
为什么偏偏是它最脏?
根源藏在鸡蛋的“出生”环节里——母鸡生蛋和排便,走的是同一个通道,这个部位叫“泄殖腔”,使得鸡蛋和鸡屎天生就容易“碰面”。
我们买回家的鸡蛋,就算表面看不到一点污渍,也不代表它真的干净,蛋壳上布满了密密麻麻的微小气孔,这些气孔肉眼很难发现,但鸡粪里的致病菌,却会借着这些小孔附着在蛋壳表面。
再加上,很多人习惯一次买很多蛋,把多余的鸡蛋放在蛋架上,裸露没有任何防护,蛋架就很容易沾染上细菌。
而且冰箱里温度虽低,却不是无菌环境,平时开关冰箱门,空气流通很容易带动细菌飘散,沾到旁边的剩菜、水果、熟食上,相当于给全家食材“交叉染菌”。
这些细菌吃进肚子里,轻一点的可能引发呕吐、腹泻、腹痛,严重一点还可能导致肠道出血、败血症、脑膜炎、流产等,甚至出现感染性休克。


来源网络
看到这有些朋友可能会想,那我把鸡蛋洗干净再放进去不就好了?
不能洗,鸡蛋表面有一层天然保护膜——角质层(也叫气孔膜),能阻挡细菌进入蛋内,同时减少水分蒸发,延长保鲜期,要是洗了它就会被破坏掉!
那我们到底该怎么做呢?
【建议】
新鲜鸡蛋买回家先用食品袋或保鲜盒装好,防止蛋壳细菌四处扩散;
每个月把蛋架拿出来消毒清洗,晾干后再放回去,减少细菌繁殖。

冯老师
高级营养师,专注于健康养身
鸡蛋一次性也要囤太多,它的保质期有限(40天左右),一般买1~2周能吃完的量就够了,这样吃得更新鲜。
2
冰箱里还有个地方
也易滋生细菌、散发异味
就是冰箱排水孔,它藏在冷藏室抽屉的上方,位置比较隐蔽,平时很难注意到。

但如果长期不清理,灰尘、食物碎屑都会堆在里面慢慢把它堵住,很多麻烦也就随之而来了:
◎冷凝水无法排出,导致积水与漏水;
◎积水过多,细菌、霉菌疯狂繁殖;
◎食物易腐败、串味,冰箱异味难除;
◎制冷效率差,能耗大特费电。

想要把排水孔清理干净,可以这么做:
①拔下电源将食物移出,用杯子往排水孔倒入少量清水,检查排水是否正常顺畅;
②用一根长约1.5米的细软管(或透孔销),从排水孔插入,轻轻推拉,将杂物清除干净;
③倒入清水观察,若排水正常表示疏通完成。


冯老师
高级营养师,专注于健康养身
注意不要用硬质铁丝,排水孔里面一般是弯曲的,强硬疏通会损伤机器线路。
搞定了这些脏地方,别以为冰箱就安全了。还有一个很多人都有的习惯,也在悄悄“喂养”冰箱细菌,给家人健康埋隐患。
3
反复解冻肉
等于在给细菌“喂饭”
生活中不少人图方便,喜欢大块大块买肉回家,往冷冻室一扔,想吃的时候就拿出来割一点,剩下的再放回冰箱冷冻,觉得低温冻着就没事。

殊不知,这样反复解冻肉才是细菌暴增的关键!
因为生肉本身就可能携带沙门氏菌、大肠杆菌、李斯特菌、肠炎耶尔森菌等细菌,放入冰箱冷冻只是抑制细菌繁殖,不是杀死细菌。

来源网络
反复解冻时,肉类的温度从零下回升到常温,温度适宜了,细菌就会疯狂繁殖,再放回冷冻室,只能再次抑制,却杀不死已经长出来的细菌,反复几次,细菌早就超标了。
另外,肉类冷冻时间太久,还会发生氧化,导致肉质变差、营养流失,也会给细菌滋生创造条件。

节目中实验发现冷冻次数越多,细菌数量越多
不同的肉保存、冷冻也有区别,下面是一些注意事项,可供参考↓↓↓
1
菜场新鲜肉
冷冻前先分装小块,吃多少拿多少,冷冻肉也别直接用保鲜膜包裹,要用食品级(PE\PP)的保鲜袋/盒包装,不然长时间接触油脂可能析出塑化剂,危害健康。
2
半成品肉(腌好的肉丝、肉馅等)
少冷冻,易影响口感、滋生细菌,冷藏别超过4天。
3
本就已经冷冻的肉
一次只拿吃的量,半年内要吃完。

冯老师
高级营养师,专注于健康养身
解冻肉时千万别用水冲,以免肉里的细菌会跟着血水跑到水槽里造成二次污染,建议提前1天放冷藏室低温解冻,或者直接用微波解冻功能。
转自:我是大医生
点击右上角
微信好友
朋友圈

点击浏览器下方“
”分享微信好友Safari浏览器请点击“
”按钮

点击右上角
QQ

点击浏览器下方“
”分享QQ好友Safari浏览器请点击“
”按钮
